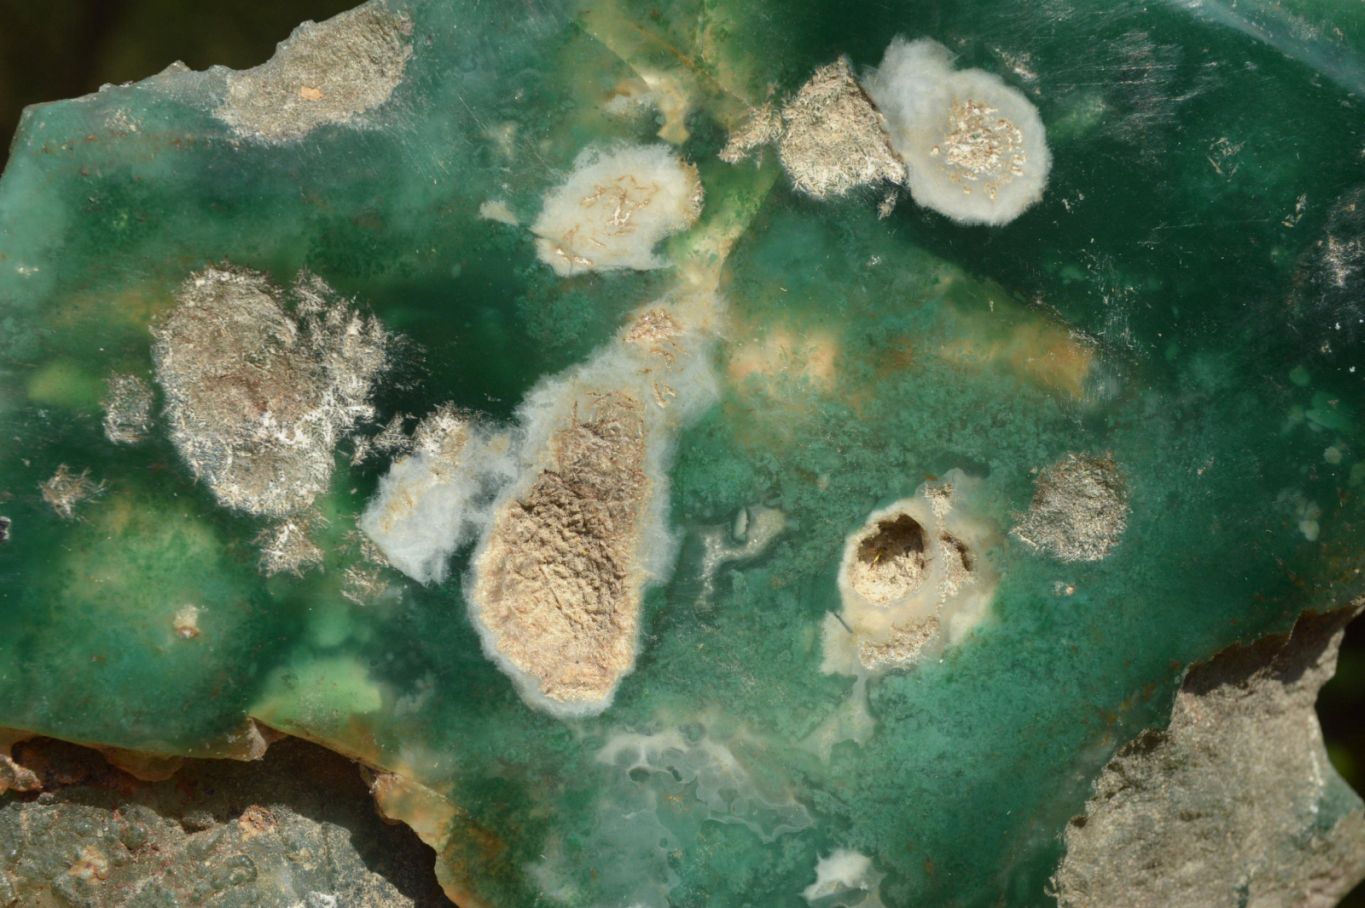
Polished Mtorolite Emerald Chrome Chrysoprase Plates x 5 From Zimbabwe - TopRock

Welcome to TOPROCKS.COM - You are shopping on our RETAIL site for worldwide customers and collectors. You are welcome to Shop and Ship any of our 20,000+ specimens with no minimum requirements. For WHOLESALE access, please Login using your 'Approved Wholesale / Trade' email address (HOW?) or email Renate@Toprocks.com

Polished On One Side Emerald Mtorolite Plates x 5 From Mutorashanga, Zimbabwe
RETAIL PRICE
PRODUCT DESCRIPTION
Mtorolite: The Exquisite Chrome Chalcedony from Zimbabwe
Emerald Mtorolite is a rare, vibrant green variety of Chrome Chalcedony found only in Zimbabwe. Its color ranges from deep forest green to a lighter emerald hue, caused by trace amounts of Chromium within its structure. This unique mineral is typically opaque with a glassy to waxy luster and is prized for its rich color, often mistaken for Jade due to its resemblance.
PRODUCT MINERALS
Chrome Chalcedony
PRODUCT FEATURES
Trigonal, Etched, Vugs-Cavities
PRODUCT COLOUR
Green
MOHS HARDNESS SCALE
6.5 to 7
PRODUCT DATA
Locality = Mutorashanga, Zimbabwe
Grade = Good to A Grade
Size = 70 - 124 mm